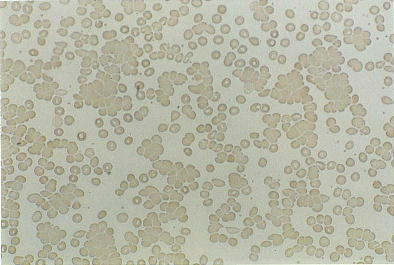

K 自己免疫性溶血性貧血
102D46
54歳の男性。倦怠感を主訴に来院した。2年前から冬季になると体調不良を自覚していた。今年の冬は1か月前から今までになく倦怠感が強くなった。同時期から,時々指尖が冷たく,痛くなた。生来健康で喫煙歴はない。意識は清明。体温 37.3℃。脈拍 96/分,整。血圧 114/58mmHg。皮膚に発疹はない。心音と呼吸音とに異常を認めない。左肋骨弓下に脾の先端を触れる。尿潜血 1+。血液所見:赤血球 252万,Hb 7.9g/dl,Ht 24%,網赤血球 4.8%,白血球 6700,血小板 34万。血液生化学所見:総蛋白 8.0g/dl,アルブミン 4.7g/dl,尿素窒素 14.0mg/dl,クレアチニン 1.0mg/dl,尿酸 7.2mg/dl,総コレステロール 220mg/dl,トリグリセライド 154mg/dl,総ビリルビン 3.2mg/dl,直接ビリルビン 0.8mg/dl,AST 35IU/l,ALT 35IU/l,LDH 770IU/l(基準 176~353),ALP 220IU/l(基準 260以下),Fe 230μg/dl,免疫学所見:CRP 0.3mg/dl,抗核抗体陰性。末梢血塗抹May-Giemsa染色標本を別に示す。
この患者に見られる検査所見はどれか。
a TSH高値
b M蛋白陽性
c 抗dsDNA抗体陽性
d 赤血球浸透圧抵抗減弱
e 直接Coombs試験陽性
× a
× b
× c
× d
○ e
正解 e
101G32
65歳の女性。坂道での動悸と息切れとを主訴に来院した。3か月前から家族に顔色不良を指摘されていた。1か月前から主訴を自覚しはじめ,徐々に悪化した。脈拍 96/分,整。血圧 134/64mmHg。表在リンパ節の腫大はない。左肋骨弓下に脾を2cm触知する。血液所見:赤沈 123mm/1時間,赤血球 145万,Hb 6.6g/dl,Ht 17%,網赤血球 23%(230‰),白血球 8900,血小板 36万。血清生化学所見:ハプトグロビン 10mg/dl以下(基準 19~170),総ビリルビン 2.7mg/dl,間接ビリルビン 1.9mg/dl,AST 50IU/l,ALT 32IU/l,LDH 650IU/l(基準 176~353)。免疫学所見:直接Coombs試験陽性,寒冷凝集反応 32倍(基準 128以下)。
治療法として適切なのはどれか。
a 蛋白同化ステロイド薬投与
b 副腎皮質ステロイド薬投与
c アザチオプリン投与
d シクロスポリン投与
e 脾摘術
× a
○ b
× c
× d
× e
正解 b
診断 温式自己免疫性溶血性貧血
99E37
自己免疫性溶血性貧血にみられる赤血球形態所見はどれか。
(1) 破砕赤血球
(2) 標的赤血球
(3) 赤血球凝集
(4) 小球状赤血球
(5) 低色素性赤血球
a (1),(2) b (1),(5) c (2),(3) d (3),(4) e (4),(5)
× (1)
× (2)
○ (3)
○ (4)
× (5)
正解 d